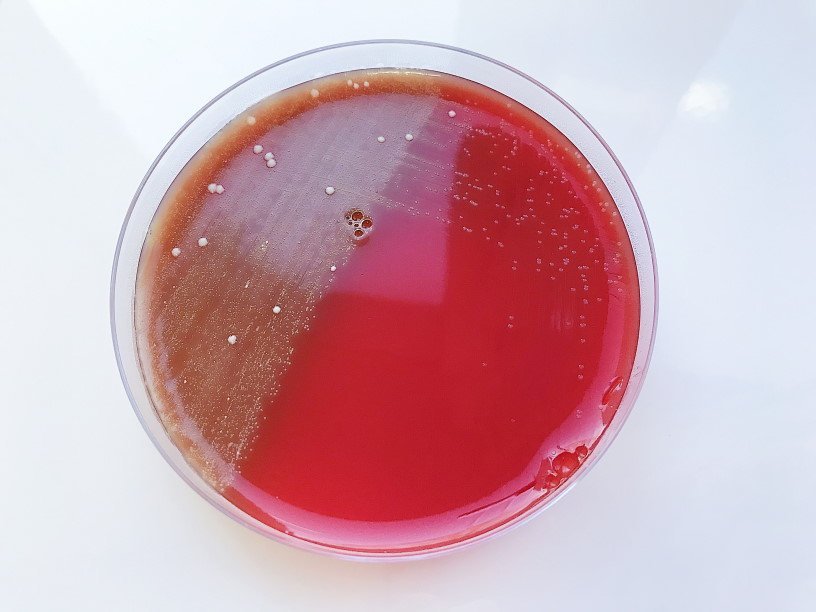

Екатерина Беленко: Промикробы: Броня крепка
Фото: Екатерина Беленко Хочешь жить — умей вертеться, а если ты очень маленький, то еще и защищаться. В защите бактериям нет равных, чего они только не придумали. Одна из самых эффективных защитных структур — клеточная стенка. Вообще клеточная стенка есть не только у бактерий, еще и у растений и грибов. Лишены этого атрибута все представители животного царства. Но клеточные стенки бактерий отличаются от растительных и грибных по составу и строению.
⠀
Клеточные стенки бактерий состоят из пептидогликана и бывают двух типов: грамположительного и грамотрицательного. Да, мы эти страшные слова уже упоминали в разговоре об окраске по Граму и микроскопии. Собственно, бактерии красятся в разные цвета именно из-за того, что у них разные клеточные стенки. Клеточная стенка грамположительного типа состоит исключительно из толстого слоя пептидогликана, плотно прилегающего к клеточной мембране. При грамотрицательном типе слой пептидогликана существенно тоньше, между ним и плазматической мембраной находится периплазматическое пространство, а снаружи клетка окружена еще одной мембраной.
⠀
У грамположительных бактерий окраска по методу Грама связана с тем, что их толстая пептидогликановая клеточная стенка прочно связывает комплекс красителя генцианвиолета с йодом, который не вымывается. Поэтому на препаратах грамположительные бактерии выглядят фиолетовыми, а у грамотрицательных бактерий этот комплекс вымывается, и они приобретают цвет второго красителя — например, сафранина. А теперь уберите от экрана беременных и впечатлительных, я собираюсь напугать вас химическими терминами. Пептидогликан — это гетерополимер N-ацетилглюкозамина и N-ацетилмурамовой кислоты, сшитый через лактатные остатки N-ацетилмурамовой кислоты короткими пептидными цепочками. Круто, правда?
⠀
Так вот, раз пептидогликан — это уникальное, свойственное исключительно бактериям вещество, да еще и жизненно важное, то совершенно логично, что он становится мишенью антибиотиков. Интересно, что из-за наличия дополнительного барьера проницаемости (наружной мембраны) для достижения необходимого эффекта грамотрицательные бактерии требуют больших концентраций антибиотиков, чем грамположительные бактерии. Некоторые антибиотики умеют блокировать образование клеточной стенки, поэтому они эффективны против самых разных бактерий. Так работает самый известный антибиотик — пенициллин. Но можно действовать иначе — разрушать уже существующую клеточную стенку. Например, фермент лизоцим способен разрушать определенные связи в молекуле пептидогликана, что фатально портит клеточную стенку, а это ведёт к гибели всего микробика. В больших количествах лизоцим содержится в слюне, чем объясняются ее антибактериальные свойства. То есть зализывать раны — не самая плохая идея.
Смотрите также: Екатерина Беленко Промикробы: Инфекция наносит ответный удар Екатерина Беленко Промикробы: С широко открытыми глазами Екатерина Беленко Промикробы: Знакомьтесь, синегнойная палочка! Екатерина Беленко Среда для микробиологов